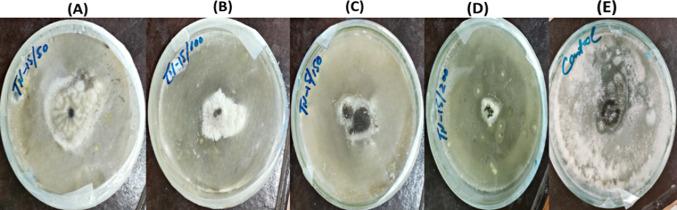
https://cdn.ncbi.nlm.nih.gov/pmc/blobs/7fc1/11447203/977d4bd7afb7/11671_2024_4076_Fig9_HTML.jpg
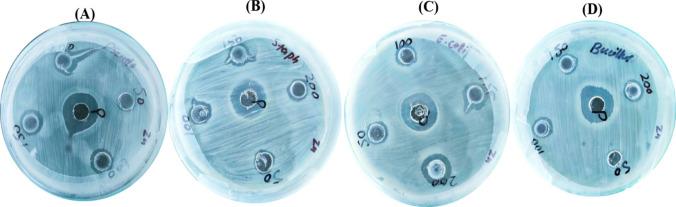
https://cdn.ncbi.nlm.nih.gov/pmc/blobs/7fc1/11447203/6cfc7140c620/11671_2024_4076_Fig7_HTML.jpg

从沙漠丝菌属TN-15细胞提取物中生物合成及表征具有抗菌、抗氧化和抗溶血性能的氧化锌纳米颗粒
Biogenic synthesis and characterization of antimicrobial, antioxidant, and antihemolytic zinc oxide nanoparticles from Desertifilum sp. TN-15 cell extract.
作者信息
Nadeem Taswar, Kaleem Muhammad, Minhas Lubna Anjum, Batool Saima, Sattar Muhammad Muzamil, Bashir Rifat, Mumtaz Abdul Samad
机构信息
Department of Plant Sciences, Faculty of Biological Sciences, Quaid-i-Azam University, Islamabad, 45320, Pakistan.
出版信息
Discov Nano. 2024 Oct 2;19(1):161. doi: 10.1186/s11671-024-04076-8.
Cyanobacteria, being a prominent category of phototrophic organism, exhibit substantial potential as a valuable source of bioactive compounds and phytonutrients, including liposomes, amino derivatives, proteins, and carotenoids. In this investigation, a polyphasic approach was employed to isolate and characterize a newly discovered cyanobacterial strain from a rice field in the Garh Moor district of Jhang. Desertifilum sp. TN-15, a unique and less explored cyanobacterial strain, holds significant promise as a novel candidate for the synthesis of nanoparticles. This noticeable research gap underscores the novelty and untapped potential of Desertifilum sp. TN-15 in the field of nanomedicine. The characterization of the biogenically synthesized ZnO-NPs involved the application of diverse analytical techniques. Ultraviolet-visible spectroscopy revealed a surface plasmon resonance peak at 298 nm. Fourier transform infrared spectral analysis was utilized to confirm the involvement of biomolecules in the biogenic synthesis and stability. Scanning electron microscopy was employed to probe the surface morphology of the biogenic ZnO-NPs unveiling their size of 94.80 nm and star-shaped. Furthermore, X-ray diffraction analysis substantiated the crystalline nature of ZnO-NPs, with a crystalline size measuring 46 nm. To assess the physical stability of ZnO-NPs, zeta potential and dynamic light scattering measurements were conducted, yielding values of + 31.6 mV, and 94.80 nm, respectively, indicative of favorable stability. The antibacterial capabilities of Desertifilum sp. TN-15 are attributed to its abundance of bioactive components, including proteins, liposomes, amino derivatives, and carotenoids. Through the synthesis of zinc oxide nanoparticles (ZnO-NPs) with this strain, we have effectively used these chemicals to generate nanoparticles that exhibit noteworthy antibacterial activity against Staphylococcus aureus (MIC: 30.05 ± 0.003 µg/ml). Additionally, the ZnO-NPs displayed potent antifungal activity and antioxidant properties, as well as significant antihemolytic effects on red blood cells (IC: 4.8 µg/ml). Cytotoxicity assessment using brine shrimps revealed an IC value of 3.1 µg/ml. The multifaceted actions of the biogenically synthesized ZnO-NPs underscore their potential applications in pharmacological and therapeutic fields. This study proposes a novel method for ZnO-NPs production utilizing the recently identified cyanobacterial strain Desertifilum sp. TN-15, highlighting the growing significance of biological systems in the environmentally friendly fabrication of metallic oxide nanomaterials.
蓝细菌作为光合营养生物的一个重要类别,作为生物活性化合物和植物营养素的宝贵来源具有巨大潜力,这些物质包括脂质体、氨基衍生物、蛋白质和类胡萝卜素。在本研究中,采用了多相方法从詹格加尔赫穆尔区的一块稻田中分离并鉴定一种新发现的蓝细菌菌株。Desertifilum sp. TN - 15是一种独特且研究较少的蓝细菌菌株,作为纳米颗粒合成的新型候选菌株具有重大前景。这一明显的研究空白凸显了Desertifilum sp. TN - 15在纳米医学领域的新颖性和未开发潜力。生物合成的氧化锌纳米颗粒(ZnO - NPs)的表征涉及多种分析技术的应用。紫外 - 可见光谱显示在298 nm处有一个表面等离子体共振峰。傅里叶变换红外光谱分析用于确认生物分子在生物合成和稳定性中的作用。扫描电子显微镜用于探测生物合成的ZnO - NPs的表面形态,揭示其尺寸为94.80 nm且呈星形。此外,X射线衍射分析证实了ZnO - NPs的晶体性质,晶体尺寸为46 nm。为了评估ZnO - NPs的物理稳定性,进行了zeta电位和动态光散射测量,分别得到+31.6 mV和94.80 nm的值,表明具有良好的稳定性。Desertifilum sp. TN - 15的抗菌能力归因于其丰富的生物活性成分,包括蛋白质、脂质体、氨基衍生物和类胡萝卜素。通过用该菌株合成氧化锌纳米颗粒(ZnO - NPs),我们有效地利用这些化学物质生成了对金黄色葡萄球菌具有显著抗菌活性的纳米颗粒(MIC:30.05±0.003 μg/ml)。此外,ZnO - NPs还表现出强大的抗真菌活性和抗氧化性能,以及对红细胞的显著抗溶血作用(IC:4.8 μg/ml)。使用卤虫进行的细胞毒性评估显示IC值为3.1 μg/ml。生物合成的ZnO - NPs的多方面作用凸显了它们在药理学和治疗领域的潜在应用。本研究提出了一种利用最近鉴定的蓝细菌菌株Desertifilum sp. TN - 15生产ZnO - NPs的新方法,强调了生物系统在金属氧化物纳米材料环境友好制造中的重要性日益增加。